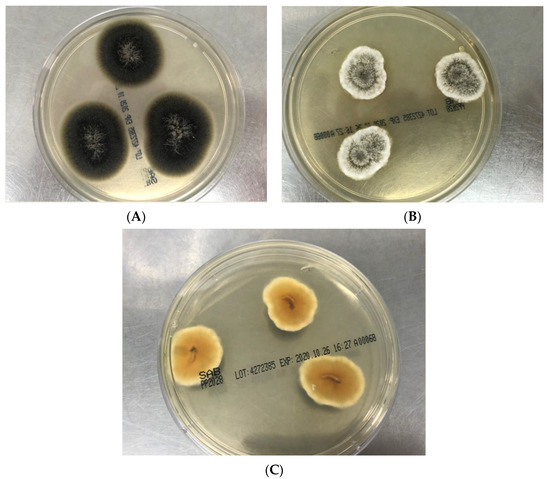

Abstract
Scedosporium/Lomentospora fungi are increasingly recognized pathogens. As these fungi are resistant to many antifungal agents, early diagnosis is essential for initiating targeted drug therapy. Here, we review the microbiological tools for the detection and diagnosis of invasive scedosporiosis and lomentosporiosis. Of over 10 species, Lomentospora prolificans, Scedosporium apiospermum, S. boydii and S. aurantiacum cause the majority of infections. Definitive diagnosis relies on one or more of visualization, isolation or detection of the fungus from clinical specimens by microscopy techniques, culture and molecular methods such as panfungal PCR or genus-/species-specific multiplex PCR. For isolation from respiratory tract specimens, selective media have shown improved isolation rates. Species identification is achieved by macroscopic and microscopic examination of colonies, but species should be confirmed by ITS with or without β-tubulin gene sequencing or other molecular methods. Matrix-assisted laser desorption ionization-time of flight mass spectrometry databases are improving but may need supplementation by in-house spectra for species identification. Reference broth microdilution methods is preferred for antifungal susceptibility testing. Next-generation sequencing technologies have good potential for characterization of these pathogens. Diagnosis of Scedosporium/Lomentospora infections relies on multiple approaches encompassing both phenotypic- and molecular-based methods.
1. Introduction
Scedosporium species and Lomentospora prolificans (formerly Scedosporium prolificans) [1] are increasingly appreciated causes of opportunistic fungal infections but can also act as primary pathogens [2,3]. Severely immunosuppressed individuals with hematological malignancies and/or stem cell or organ transplant recipients are at high risk for infection; however, immunocompetent individuals sustaining major trauma or near-drowning events are also at risk [2,4]. In addition, patients with chronic lung disease including cystic fibrosis (CF) are not uncommonly colonized with these fungi which may subsequently lead to invasive disease [2,3,4,5]. Clinical manifestations are protean. Disseminated disease is more common in immunocompromised patients with involvement of the lungs, brain, skin and heart whilst infections related to trauma or near-drowning events typically result in focal bone/joint and soft tissue, and lung and/or central nervous system (CNS) disease, respectively [2,3,4,6].
Many Scedosporium/Lomentopsora species are intrinsically resistant to current antifungal agents [7,8]. This, and their high mortality (>50%) [2,3,9], emphasize the importance of timely recognition of infection. The microbiology laboratory is central to assisting clinicians in diagnosis. It is thus apt to give pause to consider the armamentarium of diagnostic tools and how best to harness them for early diagnosis. As the clinical presentation and antifungal drug susceptibilities may be species dependent, we first briefly summarize the taxonomic classification of this group of pathogens to place diagnosis in context. We then review the microbiological diagnosis of infection with attention to traditional culture-based, molecular- and proteomic-based diagnostic approaches that can be utilized by clinical laboratories, and include drug susceptibility to current and newer antifungal agents. We conclude with a brief discussion of next generation sequencing (NGS) techniques in the diagnosis of infection.
2. Taxonomy and Species
The nomenclature of the genera Scedosporium/Pseudallescheria has undergone a number of revisions. To begin with, two species within the genus Scedosporium, Scedosporium apiospermun (with its teleomorph Pseudoallescheria boydii) and Scedosporium prolificans were recognized till the detailed application of molecular phylogenetic studies in 2005 where Gilgado at al. [10] undertook the first comprehensive review of the genus, employing four loci: β-tubulin (BT2,) TUB, calmodulin and the internal transcribed spacer regions (ITS1/2) of the rDNA gene cluster. They maintained two main “species” Scedosporium apiospermun (teleomorph P. boydii) as a species complex and Scedosporium prolificans. In addition, two new species S. aurantiacum and S. minutisporum were described. In a follow up study [11], the distinction between S. apiospermum and P. boydii was crystallized, and an additional new species, S. dehoogii, described. Further new species have since been assigned, e.g., S. deficiens (closely related to S. dehoogi), S. cereisporum (closely related to S. aurantiacum) [12,13].
With the establishment of the “One Fungus = One Name” rule in fungal taxonomy which allows only a single name per fungus [14] the genus name “Scedosporium” was retained at the expense of “Pseudallescheria. [1]. Currently, the genus Scedosporium contains at least 10 species (S. angustum, S. aurantiacum, S. apiospermum, S. boydii, S. cereisporum, S. dehoogii, S. desertorum, S. ellipsoideum, S. fusoideum, and S. minutisporium), with S. angustum, S. apiospermum, S. boydii, S. ellipsoideum and S. fusoideum considered a species complex [2]. S. apiospermum, S. boydii and S. dehoogii show extensive genetic diversity (see Figure 1 for an explanatory phylogenetic tree), suggesting the presence of cryptic species. Notably, Scedosporium prolificans was considered only distantly related to Scedosporium and was re-classified as “Lomentospora prolificans”, and the genus Lomentospora re-instated for this species [1].

Figure 1.
Phylogenetic tree of Scedosporium species based on 60 tubulin sequences (TUB, exon 5 and 6), representing the known genetic variation within the genus, using Maximum Likelihood with the K2+G model and 500 bootstrap replications. Bootstrap values >50 are given. The tree is rooted with the outgroup species Petriellopsis africana and Lomentospora prolificans. GenBank accession numbers are given in brackets behind the strain numbers. Bold font indicates sequences of type strains.
Of the species that cause disease in humans, four—Scedosporium boydii, S. apiospermum, S. aurantiacum and L. prolificans—account for the large majority of infections. Species-specific virulence, ecological, and clinical differences are described elsewhere [2,3,15,16,17] and are beyond the scope of the present review. L. prolificans is the only Lomentospora species of note that causes human disease.
3. Microbiological Diagnosis
Despite advances in non-culture-based diagnostic methods for scedosporiosis, the detection of the causative fungal agent from clinical samples by direct microscopic examination of fresh specimens, or by histopathological techniques, together with culture on mycological media remains paramount. Indeed, the 2019 updated European Organization for Research and Treatment of Cancer/Mycoses Study Group Education and Research Consortium (EORTC/MSGERC) definitions for invasive fungal disease (IFD) emphasize the visualization of fungal hyphae and/or culture of the fungus from an affected site as a criterion for proven fungal infection [18].
Molecular techniques are increasingly used to directly detect Sceodosporium/Lomentospora DNA in clinical specimens followed, typically by DNA sequencing or barcoding to identify the causative species. The use of proteomic approaches, e.g., matrix-assisted laser desorption ionization time-of-flight mass spectrometry (MALDI-TOF MS) have replaced phenotypic methods as a first line for species identification in many laboratories, backed up by molecular approaches. At present, serological methods have little role in routine diagnosis.
Finally, albeit not within scope of the present review, microbiological diagnosis should always be accompanied by imaging as appropriate to confirm diagnosis and determine the extent of infection. Recently, guidance on how to diagnose rare mold infections, including those by Sceodosporium/Lomentospora has been issued by the European Confederation of Medical Mycology in cooperation with the International Society of Human and Animal Mycoses and the American Society of Microbiology [19]. This document includes detailed recommendations on imaging.
3.1. Histopathology
Whilst the inability of histopathological methods to recognize species is acknowledged, examination by traditional stains such as the Gomori methenamie silver (GMS), hematoxylin and eosin (H & E) and periodic acid-Schiff (PAS) stains for the presence of fungal elements has good utility to provide a presumptive diagnosis of any IFD in a cost-effective manner [20]. Many experts strongly recommend such histopathological examination of affected tissue and other clinical specimens where there is a high index of suspicion for Scedosporium/Lomentospora infection. Expertise is required to distinguish the features described below.
Hyphae of Scedosporium spp. are hyaline in appearance and when visualized, confirm the presence of fungal infection, but are non-specific, and it is not possible to distinguish these from the hyphae of other hyaline molds such as Aspergillus, Fusarium and Paecilomyces spp. Nonetheless, the hyphae, typically located within areas of necrosis, are septate, non-pigmented and may show acute-angle branching. More often than not, they appear irregular, sometimes with branches bridging two parallel hyphae to form an H-shaped pattern; the last is considered by some experts to be highly suggestive of Scedosporium and L. prolificans [21]. Of note, the hyphae of L. prolificans are often, though not always, melanized [20,21]. In GMS-stained sections, lemon-shaped conidia measuring 5 × 7 µm in size may be seen, located terminally or laterally on the hyphae. Intravascular conidiation or conidiation, with purple-colored conidia, within tissue may also be evident [2,21]. Thrombosis of blood vessels is usual. In brain tissue, granulomatous inflammation with multinucleate giant cells and hyphae within the cerebral vasculature are described [22]. Whilst in situ hybridization with a Scedosporium-specific DNA probe has been reported [23], its utility in routine diagnostics is uncertain.
3.2. Microscopy and Culture
Despite the fact that microscopy and culture are insensitive and slow (2–10 days), their application to clinical specimens remains a cornerstone of diagnosis. Further, culture yields an isolate for drug susceptibility testing.
These fungi can be cultured from any clinical specimen including tissue, respiratory tract specimens, eye, skin and blood. Both Scedosporium spp. and L. prolificans will grow in standard blood culture systems although most publications describe the recovery of L. prolificans from blood cultures (summarized in 2, 3, 6). More often, however, these fungi are recovered from sputum and respiratory tract samples including bronchoalveolar lavage (BAL) fluid. Isolates from sterile sites should always be considered clinically significant. Direct microscopy of clinical specimens can rapidly suggest a diagnosis in appropriate clinical context. Yeast-to-hyphal structures may be seen on Gram stain of blood cultures. There are few data on use of fluorescent brighteners or potassium hydroxide (KOH) wet mounts, the latter of which is limited to skin and corneal scrapes.
3.2.1. Culture
Scedosporium/Lomentospora fungi will grow without difficulty on standard mycological media such as Sabouraud’s dextrose agar (SDA) or potato dextrose agar (PDA). However, their recovery especially from non-sterile respiratory tract specimens may be hampered by competing growth from other fast-growing molds, most often Aspergillus spp., leading to “missed” detection. It is also important to note that the growth of L. prolificans, but not Scedosporium spp., is inhibited by the presence of cycloheximide, if added to mycological media [3].
Hence, many laboratory mycologists choose to employ the use of semi-selective or selective media to “select” for growth of Scedosporium/Lomentospora spp. This involves the incorporation of an inhibitor, such as benomyl, cycloheximide (Scedosporium spp.) or dichloran (2,6-dichlro-4-nitroaniline) to inhibit non-Scedosporium/Lomentospora fungi into a base medium to reduce growth of other molds. Such media include Scedosporium Selective agar (SceSel+) and its newer variation Scedo-Select III which contains both benomyl and dichloran [24,25] which is preferred but these must be freshly prepared and are not available commercially. Alternatives are Dicloran Rose Bengal Chloramphenicol medium (DRBC, ThermoScientific, Oxoid, UK), which also contains benomyl [26], and MycoselTM agar (BBL, BD, USA), both of which may be purchased although the latter was found in one study to be inferior to SceSel+ agar for recovery of Scedosporium from sputum [27]. Most experts recommend the combination of non-selective media, e.g., SDA with selective media, preferably SceSel+ or DRBC. Fungal colonies grow within 48–72 h and then are subcultured onto PDA at 25 °C for 10–14 days, to enable slide cultures for delineating microscopic characteristics of colonies.
Although many laboratories now rely on molecular-based methods to confirm species identification, there are phenotypic features from cultured colonies that can assist identification, briefly summarized in Section 3.2.1.1 and Section 3.2.1.2 below. Key macroscopic and microscopic features of the major medically important Scedosporium/Lomentopsora species are given in the tables below.
3.2.1.1. Macroscopic Features
Most Scedosporium spp. and L. prolificans will be sufficiently mature in growth on PDA to allow elucation of macroscopic and microscopic characteristics. One distinguishing feature of L. prolificans from Scedosporium species is its grey-back color (Figure 2A) and its susceptibility to cycloheximide [3]. The variation of colony color of S. apiospermum, S. boydii and S. aurantiacum are given in Table 1. Colonies of S. aurantiacum are often seen in a pattern of concentric growth (representing aerial mycelium, Figure 2B), which varies from yellow to gray/brown in color; further, many isolates produce a distinctive yellow diffusible pigment on PDA after few days’ incubation (Figure 2C). S. aurantiacum is also able to grow at 45 °C. Table 1 shows that the colony characteristics of S. apiospermum and S. boydii are very similar if not identical and these species are unable to be distinguished from each other [11].
Figure 2.
(A): Flat, spreading olive-grey to black colored and suede-like surface (obverse view) of Lomentospora prolificans on Sabouraud dextrose agar (SDA) after four days growth at 28 °C. (B): Greyish-white cottony to woolly surface with concentric growth pattern and white margins (obverse view) of Scedosporium aurantiacum on SDA after 3 days growth at 28 °C. (C): Brown orange center with pale yellow pigment (reverse view) of Scedosporium aurantiacum on potato dextrose agar after 3 days incubation at 28 °C.

Table 1.
Colony morphology, color, and growth characteristics of Scedosporium and Lomentospora prolificans on potato dextrose agar [11,28].
3.2.1.2. Microscopic Features
Microscopic features may suggest the presence of L. prolificans and disitinguish it from Scedosporium spp., notably the visualization of flask-shaped conidiophores which are inflated or swollen at the base, from which single, or clusters of conidia emerge (Figure 3A,B). Species distinction within the S. apiospermum species complex is not possible (Table 2). The teleomorph state (where known) and characteristics of cleistothecia (or closed spore-bearing structures), ascopores and conidia (shape and wall thickness) for the major species are shown in Table 2 with detailed descriptions elsewhere [2,11,28]. For S. aurantiacum, coniodiophores are solitary and borne on aerial mycelium. Conidia are typically smooth, and thick walled, and often obovoid in shape [2,28].

Figure 3.
A and B: Microscopic morphology of Scedosporium aurantiacum (A) and Lomentospora prolificans (B) 40x magnification. (A) Hyphae are septate with simple long conidiophores (arrow) bearing conidia singly or in small groups. Conidia (4–9 × 6–10 μm) are single-celled, pale brown ovoid in shape and are rounded above with truncated bases. (B) Hyphae are hyaline and septate with conidia born in small groups on basally swollen, flask-shaped conidiophores (arrow). Conidia (2–5 × 3–7 μm) are hyaline to pale brown, one-celled and oval-shaped with smooth walls.

Table 2.
Microscopic features of Scedosporium species and Lomentospora prolificans.
3.3. Species Identification
3.3.1. Phenotypic Methods
Phenotypic identification methods include growth at 40 °C and 45 °C (Table 1), pattern of utilization of carbohydrates and enzymatic activities. Although collectively these can aid in species differentiation, they are not able to separate species within the S. apiospermum complex. In some laboratories, time-consuming “in-house” systems are used. Commercial kits for species identification include the Taxa Profile MicronautTM (Marlin Diagnostika GmbH, Berlin, Germany), a system examining various physiological reactions of these fungi [29], and the GEN III MicroPlateTM (Biolog Inc., Hayward, CA, USA) [30]. However, the latter was set up to distinguish between high- and low-virulent strains of S. aurantiacum rather than for species identification. In practice, phenotypic methods are largely superseded by MALDI-TOF MS and molecular approaches.
3.3.2. MALDI-TOF MS
Although multi-locus DNA sequencing is considered the reference method (see later), MALDI-TOF MS offers good potential for fast, and relatively economical identification of Scedosporium species and L. prolificans with comparable accuracy to many molecular methods with the proviso that MS databases contain reference spectra [31]. The standardisation of growth conditions for fungal protein extraction and of methods for extended sample preparation to achieve good quality mass spectra is also essential [32]. The Vitek® MS v3.0 (bioMerieux, Marcy L’Etoile, France) database was approved by the US Food and Drug Administration (FDA) for identification of molds in July 2017, but does not contain spectra of S. aurantiacum. Consequently, within the S. apiospermum complex, only S. apiospermum and S. boydii can be identified by the Vitek® MS v 3.0 system [33]. The other commercial MALDI-TOF MS systems (MALDI Biotyper (Bruker Daltonics, Bremen, Germany), Andromas (Andromas SAS, Paris, France) and Axima@SARAMIS (Shimadzu/AnagnosTec, Duisburg, Germany)) are also inadequate for the identification of Scedosporium/Lomentospora when relying on their database alone [34,35,36]. As such, the success of MALDI-TOF MS is enabled by complementation of commercial databases by in-house libraries together with consistency of sample preparation methods used to generate these mass spectra [32,37].
Sleiman et al. [34] reported a 5-fold improvement (18 to 94%, n = 17) in the identification of Scedosporium/Lomentospora isolates (score values ≥ 2.00) after the Bruker Filamentous Fungi Library v1.0 (Bruker Daltoniks) was supplemented with an in-house database. Although L. prolificans was represented in the Bruker database, only one of four strains was identified, yet all four were identified using the enhanced database, suggesting test performance also relies on the inclusion of spectra from local strains in the database. In another study, only one of 21 Scedosporium spp. isolates were correctly identified to genus level using the same Bruker library. The inclusion of 24 reference spectra from S. boydii, S. apiopsermum and L. prolificans to an in-house database allowed 76% (16/21) of isolates to be identified to species level but with scores of 1.65–1.9 [38].
Of note, Sitterle et al. [36] built a reference database comprising L. prolificans and five morphologically indistinguishable species—S. boydii, S. apiosperum, S. aurantiacum, P. minutispora and S. dehoogii for use on the Andromas platform. The database was evaluated against 64 isolates previously identified by multi-locus sequence type (MLST) analysis, and all isolates were unequivocally identified in minutes (vs. several days for MLST), demonstrating the power of MALDI-TOF MS with a comprehensive database. However, a similar study [35] using reference spectra from an online database was unable to distinguish within the S. apiospermum complex.
3.3.3. Identification by Molecular Methods (Isolates)
DNA sequence-based analysis is the current “gold standard” for species identification of all fungi. Sequencing of the primary fungal DNA barcode, the ITS region is able to identify the main pathogenic species of Scedosporium/Lomentospora [39]; however, for very closely related species, e.g., S. boydii and S. ellipsoidea (an environmental species) [1], amplification of an additional locus, the partial β-tubulin gene (βT2) may be required to resolve species. Of central importance is a reliable reference sequence database such as those of the Westerdijk Institute (http://www.westerdijkinstitute.nl/Collections/BioloMICSSequences.aspx) or the International Society for Human and Animal Mycology (http://its.mycologylab.org) for sequence pairwise alignment.
Other than DNA sequencing, the analysis of repetitive DNA sequences of isolates (rep-PCR) using the DiversilabTM System (bioMerieux) enabled not only the identification of a number of Scedosporium species but also identified genotypes within species [40]; of a total of 63 isolates, rep-PCR identified eight genotypes each of S. apiospermum and S. boydii whilst all S. aurantiacum isolates shared the same profile. Rep-PCR profiles were concordant with their MLST (see below).
To this end, species identification may also be undertaken by MLST as inferred in Section 3.3.2 with at least three web-based MLST schemes available for comparison of MLST genotypes—one each for S. apiospermum, S. boydii and S. aurantiacum (https://mlst.mycologylab.org) [41]. However, MLST does not readily translate to routine use in diagnostic laboratories and requires expertise for set up and interpretation.
Finally, rolling circle amplification (RCA) which uses a simple isothermal amplification format can differentiate between sequences to a single nucleotide level [42]. Using an ITS-directed RCA to identify Scedosporium species, Zhou et al. distinguished between L. prolificans and S. apiospermum/S. boydii [43]. The advantages of RCA are that procedures can be performed rapidly (within 2 h) and with a simple heating block or water bath, with simplicity and cost effectiveness.
3.4. Direct Detection in Clinical Specimens by Molecular Methods
The high resolving power together with increasing access to molecular biology technologies in clinical laboratories have enhanced the laboratory’s capacity to rapidly detect and identify Scedosporium/Lomentospora fungi directly from clinical specimens. Such approaches include broad range PCR followed up by DNA sequencing and species-specific multiplex PCR in various formats including real time PCR and oligonucleotide arrays. Each has its relative strengths and uptake of technology is dependent on laboratory resources. There are no standadized commercial assays.
3.4.1. Broad Range PCR
Broad range or panfungal PCR is increasingly employed in clinical laboratories to identify fungi directly from fresh and formalin fixed paraffin-embedded (FFPE) tissue as well as from other types of clinical specimens including BAL fluid and cerebrospinal fluid (CSF). Multiple assays have been published [44,45,46]. Most often, the ITS regions (ITS1, ITS2 or both) or the 28S rDNA locus are amplified using universal fungal primers [47] followed by DNA sequencing [48], although high-resolution melt curve analysis by real-time PCR is increasing [49,50,51]. Species identification of by sequencing would follow the same principles as those of cultured isolates (Section 3.3.3). In general, accuracy and specificity are good although sensitivity varies with specimen type.
In one report, using a panfungal real-time PCR, test performance was best when used on sterile body fluids (sensitivity 100%, specificity 96%, negative predictive value (NPV) 100% and positive predictive value (PPV) 86%)) but performance was considerably lower when performed on BAL fluid (90%, 75%, 86% and 82%, respectively) [51]. Gomez et al. using a sequence-based PCR observed a sensitivity and specificity of 96.1% and 98.2%, respectively, in patients with proven IFD (n = 60). Assay sensitivity was similar across different specimen types (100% for fresh tissue, 100% for sterile body fluids and 90% for FFPE) [46]. These two sets of findings saw a greater sensitivity than that reported by others [48,52] where using an ITS-1 targeted panfungal PCR Lau et al. [48] made the point that sensitivity is highest when fungal elements were visible in fresh or histopathological sections. Assay sensitivity, which included the detection of L. prolificans in tissue, was 97% when applied to fresh tissue and 68% when performed on FFPE tissue [48]. For 20 culture-negative but histopathology-positive specimens reported by Trubiano and colleagues, diagnosis of IFD to causative species level by panfungal PCR occurred in 35% (6/20) [52]. In support of the above, the 2019 updated EORTC/MSGERC IFD definitions recommend the amplification of fungal DNA by PCR combined with DNA sequencing only when fungal elements are seen on histopathology specimens or sterile body fluids [18]. Under these circumstances, the assay has good utility and value adds to the diagnostic approach (Figure 4).

Figure 4.
Workflow for diagnosis of invasive Scedosporium and Lomentospora prolificans infections. CLSI = Clinical and Laboratory Standards Institute; EUCAST = European Committee on Antimicrobial Susceptibility Testing; rDNA = ribosomal DNA; ID = identification; ITS = internal transcribed spacer; MALDI-TOF MS = matrix-assisted laser desorption/ionization time-of-flight mass spectrometry; PCR = polymerase chain reaction; PDA = Potato dextrose agar; TUB = Tubulin.
Of note, ITS-directed assays may not be able to distinguish between species within the S. apiospermum complex, as no DNA barcoding gap is present, due to the relatively large degree of genetic variation found in this species complex. The use of alternative loci, such as the βT2 gene, TUB and elongation factor 1 alpha genes may be necessary (see Figure 5).

Figure 5.
Distribution of interspecies (blue line) and intraspecies (red line) pairwise Kimura 2-parameter genetic distances in the genus Scedosporium based on the primary fungal DNA barcode the ITS1/2 region, based on 60 ITS1/2 sequences of Scedosporium angustum, Scedosporium aurantiacum, Scedosporium apiospermum, Scedosporium boydii, Scedosporium cereisporum, Scedosporium dehoogii, Scedosporium desertorum, Scedosporium ellipsoideum, Scedosporium fusoideum and Scedosporium minutisporum. No DNA barcoding gap was identified using the ITS1/2 region. All taxa were subjected to pairwise sequence divergence calculations using the Kimura 2-parametric distance model (K2P) in MEGA ver. 5.2.2.
Conversely, the interpretation of broad range PCR results when performed on non-sterile specimens especially on BAL fluid is problematic and PCR-positive results cannot discriminate between lung infection and airway colonization. Sensitivity of panfungal PCR on BAL fluid is also lower in patients receiving mold-active therapies [52].
Finally, Salehi et al. used multiple real-time quantitative PCR assay targeting the ITS2 region to identify Scedosporium/L. prolificans in a variety of FFPE specimens where fungal elements were seen. [50]. Probes used included a pan-“Scedosporium” probe, and one each for S. apiospermum, L. prolificans and S. aurantiacum. The study was limited in that only a single specimen was identified as containing DNA from these fungi.
3.4.2. Targeted Multiplex PCR
There are relatively few reports on the use of multiplex PCR for the specific detection of Scedosporium/Lomentopsora in clinical specimens. Using species-specific ITS-directed primers as well as those targeting the 28S rDNA gene, one study used standard multiplex PCR to detect L. prolificans, S. apiospermum complex and S. aurantiacum on DNA extracts from stored sputum specimens from CF patients, in comparison with culture. The PCR yielded a positive result in 18/29 samples from 7/11 (63.6%) patients; the test specificity was 97.2% with a PPV of 78.3% and NPV of 94.1% [53]. Insufficient target DNA and PCR inhibition can limit test sensitivty. Although simple, at present, direct muitpelx PCR should complement culture, rather than replace it.
Mulitplex PCRs may also be in real time format using fluorescent-labelled primers, probes or dyes. Experience with such PCR assays to detect and identify Scedosporium species in routine diagnostics is limited. Castelli et al. developed two separate ITS-targeted PCR assays for species identification of L. prolificans and S. apiospermum and tested their assay in infected mice. In mice infected with L. prolificans, the assay sensitivity was 95.5% for lung tissue, 85% for serum and 83.3% for whole blood. For S. apiospermum infected mice the sensitivity of the assay was 97.2%, 81.8% and 54.5% for lung, serum and blood, respectively [54].
3.4.3. Oligonucleotide Array Assay
Bouchara et al. [55] were one of the first to apply this technology to direcly detect fungi including Scedosporium in the sputum of CF patients. For 57 sputa, results were compared with those of culture. In more than half the cases (n = 33 samples), the array detected a more diverse range of fungi than culture. Scedosporium fungi were identified but not at species level. Disadvantages include the high costs for set up and need for batch testing for efficiencies.
3.5. Serology
Diagnosis by serological approaches have encompassed the study of both panfungal biomarkers as well as Scedosporium/Lomentospora-specific markers. However, large scale studies on their diagnostic utility remain sparse. The best studied panfungal marker is 1,3-β-D-glucan (BDG) which is found in the cell wall of fungi and can be detcted in the blood of patients with IFDs except in Mucorales and Cryptococcus infections. The clinical utility of this test is well summarized by meta-analyses [56,57] and demonstrates generally good sensitivity and specificty (for any IFD) in various patient populations. This has typically included a small number of patients with Scedosporium and L. prolificans infections and is supported by the detection of BDG in serum in reports of Scedosporium brain abscess and L. prolificans fungemia [58,59,60]. The serum BDG test may thus be a useful diagnostic adjunct. Most studies have employed the FungitellTM assay (Associates of Cape Cod inc.; Falmouth, MA, USA).
There are no comemrcial Scedosporium or L. prolificans-specific serological tests. Nonetheless, Thornton and colleagues have develoepd a number of Scedosproium-Lomentopsora specific monoclonal antibodies (Mabs) that enable species identification. One targets an extracellular 120-kDa antigen located in the spore and hyphal walls of S. apiospermum and S. boydii whilst the other tragets the enyme tetrahydroxynaphthalene reductase which plays a role in the biosysnthesis of melanin in L. prolificans [61,62]. Certain Scedosporium proteins such as cytosolic catalase have been studied as markers of infection as have various metabolites and siderophores [63,64] of these fungi, but currently these markers are limited to research laboratories. Mina et al. reported that sera of CF patients with S. apiospermum complex infection demonstrated antibodies to catalase A1 of S. boydii by ELISA whilst those colonized or infected with Aspergillus fumigatus did not [63]. Study in different patient cohorts is warranted to investigate the role of novel antigen/antibody tests in serodiagnosis.
3.6. In Vitro Susceptibility to Antifungal Agents
Scedosporium/Lomentospora fungi are resistant to many antifungal agents currently available. As there are species-specific susceptibility patterns, it is imperative the causative species is accurately identified. Further within species, minimum inhibitory concentrations (MICs) to some antifungal drugs vary between isolates, rendering it advisable to determine drug MICs to all clinically significant isolates. The methodology chosen should be an established method such as the reference broth microdilution methods of the Clinical Laboratory Standards Institute (CLSI), USA and the European Committee on Antimicrobial Susceptibility Testing (EUCAST; www.eucast.org). Where the commercial Sensititre® Y010 panels are used (Trek Diagnostics Systems, ThermoFisher, Waltham, MA, USA).), comparative evaluations are recommended but in general, similar MIC results have been obtained [65,66,67].
All Scedosporium species and L. prolificans are resistant to amphotericin B (MIC90 generally 8—>32 mg/L), 5-flucytosine (MIC90 > 16 mg/L), fluconazole (MIC90 > 16 mg/L) and itraconazole (16—>16 mg/L) although a number of studies have observed that S. apiospermum complex isolates may exhibit lower MICs to itraconazole (MIC 0.5–1 mg/L) [8,66,67]. In addition, both genera have reduced susceptibility to the echinocandins with wide ranging MICs (MICs 0.006–32 mg/L) reported, with L. prolificans being the most “resistant’ (MICs 4–16 mg/L) [8,67]. However, for voriconazole, geometric mean (GM) MICs are relatively low for S. apiopermum and S. boydii (GM MIC 1.64 and 0.75 mg/L respectively) with similar observations for posconazole. Notably, L. prolificans is pan-antifungal resistant [2,8,66,68].
L. prolificans is also resistant to isavuconazole (MICs typcially > 4 mg/L), [8,66,68,69], however Trovato et al. observed lower MICs for isavuconazole among 27 S. apiospermum complex strains using both the EUCAST E. Def. 9.3 (GM MIC 1.22 mg/L) and the Etest (Liofilchem, TE, Italy; GM MIC 1.08 mg/L) [70]. Terbinafine MICs also vary with species between 0.06–32, being lowest for S. apiospermum [67]. Although terbinafine is not a drug that is used alone for treatment of L. prolificans infections, it demonstrates in vitro synergy with voriconazole and to a lesser extent with posaconazole and is used in combination typically with voriconazole [2,71,72]. The treatment of infections caused by these fungi are beyond the scope of this review but can be found in recent management guidelines [19,72].
New Antifungal Drugs in the Pipeline
It is pertinent to briefly touch on a number promising novel antifungal drugs for treatment of Scedosporium and L. prolificans infections. In due course, it could be argued that clinical laboratories will consider the inclusion of these agents in their antifungal susceptibility testing menu.
Fosmanogepix (formerly APX001 and E1211) is a new first-in-class antifungal with broad spectrum activity which targets the inositol acylation step in the biosynthesis of the glycosyl phosphatidyl inositol (GPI) anchor, which in turn anchors proteins to the cell wall [73]. In vitro testing of S. apiospermum (n = 28), S. aurantiacum (n = 7) and L. prolificans (n = 28) revealed that MICs were at least 10-fold lower than found for standard antifungal drugs including voriconazole [74]. The MEC90 values for fosmanogepix against both S. apiospermum and L. prolificans were 0.12 mg/L [74]. Another particularly promising anti-Scedosporium and L. prolificans agent is Olorofim (previously F901318). Olorofim is a first-in-class antifungal drug that inhibits dihydroorotate dehydrogenase, an enzyme central to fungal pyrimidine biosynthesis [75]. Biswas et al. tested 50 strains encompassing the four main species with MICs ranging between 0.125–0.5 mg/L [8]; similar results were reported in a US study (MIC range <0.008–0.25 mg/L) with L. prolificans strains having MICs at the upper end of the range [76]. Finally, N-chlorotaurine (NCT) has broad spectrum antimicrobial killing activity due to its transhalogenated nature, which markedly enhances its in vivo activity. Clinical phase I and II studies have demonstrated good tolerability of topical 1% NCT in aqueous solution including during inhalation [77]. Whether these results can be translated into treatment of scedosporiosis in the lung is not yet known.
3.7. Diagnostic Algorithms in the Microbiology and Pathology Laboratories
Given the many options for laboratory diagnosis, a systematic guide to assist laboratories with diagnosis is helpful. Whether a diagnostic approach is performed will be partially dependent on access, resources and on the size and nature of the laboratory (e.g., a reference mycology laboratory vs. a smaller district hospital). Figure 4 summarizes a diagnostic pathway for both invasive infections due to Scedosporium spp. and L. prolificans. To re-emphasize, imaging procedures are essential parallel investigations. The Global guideline for the diagnosis and management of rare mold infections refer to the strength of recommendations for each diagnostic option and give the rationale behind these recommendations [19].
4. Next Generation Sequencing Approaches
Given the increasingly emergent nature of Scedosporium/Lomentospora infections, the publishing of the draft genomes, using next generation sequencing (NGS) methodology, of all four major pathogenic species is welcomed [78,79,80,81]. Both short read sequencing using Illumina technology (Illumina Inc., San Diego, CA, USA) and long read sequencing for additional coverage using Oxford Nanopore Technology with the MinION (ONT, Didcot, Oxford, UK) [78] have been used. Genome sizes are similar and typical for a filamentous fungus, very large (37.6 Mb, 43.3 Mb, 43.4 Mb and 39.9 Mb for L. prolificans, S. boydii, S. apiospermum and S. aurantiacum, respectively) [78,79,80,81]. Genomes have been annotated or genes, predicted. Chromosomal analysis has revealed that L. prolificans contains at least 7, and possibly 11 chromosomes [78]. Of note, analysis has been undertaken using different bioinformatic tools and more study is required to understand the comparability of these results. The clinical application of NGS of Scedosporium/Lomentospora isolates using these draft genomes as a “reference” is ongoing.
As such, there are few data on the use of NGS to study genomic relationships of clinical strains and in the tracking of infection. One small study investigated a possible link between four L. prolificans isolates from infections occurring over an 8-month period a single hospital unit [82]. There were >10,000 single nucleotide polymorphisms (SNPs) between isolates. However, there were sparse details given as to how analysis was undertaken to for SNP calling, and the results were inconclusive to establish a genetic relationship. Study of larger numbers of isolates of each of these species in clinical context is required to determine the genetic variation as occurs in cases of sporadic infection to inform relatedness in event of case clusters. Results analyzed by different bioinformatic pipelines will influence interpretation and it is also important the ploidy of these fungi are taken into consideration when studying genetic polymorphisms.
5. Conclusions
In conclusion, the microbiology-pathology laboratory has good potential to assist with diagnosis of Scedosporium and L. prolificans infections. With wider access to molecular detection and identification methods, it is tempting for laboratories to reduce focus on culture and conventional identification methods as these are time consuming and require trained personnel. However, in many resource-limited settings, culture and phenotypic approaches remain mainstay of diagnosis; in this context, access to MALDI-TOF MS and molecular-based methods are a priority. It should be noted, however, that basic biology and morphology is still required for characterization of fungi and represents a criterion for the lodging of authenticated fungal strains in a recognized and curated culture collection. Hence it is important for laboratories to maintain an understanding of all diagnostic approaches.
The role of NGS genomics is currently still largely research based. Improved and standardized approaches to bioinformatic analysis of data would help position this technology into being translated into routine use.
Author Contributions
Conceptualization, S.C.-A.C.; methodology, S.C.-A.C., C.L.H., M.H., O.A.C. and W.M.; formal analysis, S.C.-A.C., C.L.H., M.H., O.A.C. and W.M.; investigation, S.C.-A.C., C.L.H., M.H., O.A.C. and W.M.; resources, S.C.-A.C., C.L.H., M.H., O.A.C. and W.M.; data curation, S.C.-A.C., C.L.H. and W.M.; writing-original draft preparation, S.C.-A.C., C.L.H. and W.M.; writing—review and editing, S.C.-A.C., C.L.H., M.H., O.A.C. and W.M.; visualization, S.C.-A.C., C.L.H., M.H. and W.M.; project administration, S.C.-A.C. All authors have read and agreed to the published version of the manuscript.
Funding
This work was supported in part by an NHMRC grant # APP1121936 to W.M. and S.C.-A.C.
Data Availability Statement
Not applicable. Invited review.
Acknowledgments
The authors thank Alex Khan and Laszlo Irinyi, Molecular Mycology Research Laboratory, University of Sydney for their invaluable assistance with the sequence and DNA barcoding analysis.
Conflicts of Interest
All authors declare no conflict of interest for the submitted work. Outside the submitted work: CH and WM: no conflicts of interest.SC-AC reports untied educational grants from MSD Australia and F2 G Ltd., and is advisor to MSD Australia and F2G Ltd. MH reports research grants from Gilead, Pfizer and Astellas. OAC is supported by the German Federal Ministry of Research and Education, is funded by the Deutsche Forschungsgemeinschaft (DFG, German Research Foundation) under Germany’s Excellence Strategy—CECAD, EXC 2030—390661388 and has received research grants from, is an advisor to, or received lecture honoraria from Actelion, Allecra Therapeutics, Al-Jazeera Pharmaceuticals, Amplyx, Astellas, Basilea, Biosys, Cidara, Da Volterra, Entasis, F2G, Gilead, Grupo Biotoscana, IQVIA, Janssen, Matinas, Medicines Company, MedPace, Melinta Therapeutics, Menarini, Merck/MSD, Mylan, Nabriva, Noxxon, Octapharma, Paratek, Pfizer, PSI, Roche Diagnostics, Scynexis, and Shionogi.
References
- Lackner, M.; De Hoog, S.; Yang, L.; Moreno, L.F.; Ahmed, S.A.; Andreas, F.; Kaltseis, J.; Nagl, M.; Lass-Flörl, C.; Risslegger, B.; et al. Proposed nomenclature for Pseudallescheria, Scedosporium and related genera. Fungal Divers. 2014, 67, 1–10. [Google Scholar] [CrossRef]
- Cortez, K.J.; Roilides, E.; Quiroz-Telles, F.; Meletiadis, J.; Antachopoulos, C.; Knudsen, T.; Buchanan, W.; Milanovich, J.; Sutton, D.A.; Fothergill, A.; et al. Infections caused by Scedosporium spp. Clin. Microbiol. Rev. 2008, 21, 157–197. [Google Scholar] [CrossRef] [PubMed]
- Ramirez-Garcia, A.; Pellon, A.; Rementeria, A.; Buldain, I.; Barreto-Bergter, E.; Rolilin-Pinheiro, R.; de Meirelles, J.V.; Xisto, M.; Ranque, S.; Havlicek, H.; et al. Scedosporium and Lomentospora: An updated overview of underrated opportunists. Med. Mycol. 2018, 56, S102–S125. [Google Scholar] [CrossRef] [PubMed]
- Slavin, M.A.; van Hal, S.; Sorrell, T.C.; Lee, A.; Marriott, D.; Daveson, K.; Kennedy, K.; Hajkowicz, K.; Halliday, C.; Athan, E.; et al. Invasive infections due to filamentous fungi other than Aspergillus: Epidemiology and determinants of mortality. Clin. Microbiol. Infect. 2015, 21, 1e.1–1e.10. [Google Scholar] [CrossRef]
- Schwartz, C.; Brandt, C.; Antwieler, E.; Karanich, A.; Staab, D.; Schmitt-Grobe, S.; Fischer, R.; Hartl, D.; Thronicke, A.; Tintelnot, K. Prospective multicenter German study on pulmonary colonization with Scedosporium/Lomentopsora species in cystic fibrosis: Epidemiology and new association factors. PLoS ONE 2017, 12, e00171485. [Google Scholar]
- Kell, M.; Stevens, R.; Konecny, P. Lomentospora prolificans endocarditis—case report and literature review. BMC Infect. Dis. 2016, 16, 36. [Google Scholar] [CrossRef] [PubMed]
- Lackner, M.; Hagen, F.; Meis, J.F.; Ende, A.H.G.G.V.D.; Vu, D.; Robert, V.; Fritz, J.; Moussa, T.A.A.; De Hoog, G.S. Susceptibility and diversity in the therapy-refractory genus Scedosporium. Antimicrob. Agents. Chemother. 2014, 58, 5877–5885. [Google Scholar] [CrossRef]
- Biswas, C.; Law, D.; Birch, M.; Halliday, C.; Sorrell, T.C.; Rex, J.; Slavin, M.; Chen, S.C.-A. In vitro activity of the novel antifungal compound F901318 against Australian Scedosporium and Lomentospora fungi. Med. Mycol. 2018, 56, 1050–1054. [Google Scholar] [CrossRef]
- Jenks, J.D.; Seidel, D.; Cornely, O.A.; Chen, S.; van Hal, S.; Kauffman, C.; Miceli, M.H.; Heinemann, M.; Christner, M.; Saenz, A.; et al. Clinical characteristics and outcomes of invasive Lomentospora prolificans: Analysis of patients in the FungiScopeR registry. Mycoses 2020. [Google Scholar] [CrossRef]
- Gilgado, F.; Cano, J.; Gené, J.; Guarro, J. Molecular Phylogeny of the Pseudallescheria boydii species complex: Proposal or two new species. J. Clin. Microbiol. 2005, 43, 4930–4942. [Google Scholar] [CrossRef]
- Gilgado, F.; Cano, J.; Gene, J.; Sutton, D.A.; Guarro, J. Molecular and phenotypic data supporting distinct species statues for Scedosporium apiospermum and Pseuadlescheria boydii and the proposed new species Scedosporium dehoogii. J. Clin. Microbiol. 2008, 46, 766–771. [Google Scholar] [CrossRef] [PubMed]
- Rainer, J.; Kaltseis, J. Diversity in Scedosporium dehoogii (Microascaceae): S. deficiens sp. nov. Sydowia 2010, 62, 137–147. [Google Scholar]
- Crous, P.W.; Wingfield, M.J.; Burgess, T.I.; Hardy, G.E.; Crane, C.; Barratt, S.; Cano-Lina, J.F.; Le roux, J.; Thangevel, R.; Guarro, J.; et al. Fungal planet description sheets: 469–557. Personia 2016, 37, 218–403. [Google Scholar] [CrossRef]
- Hawksworth, D.L.; Crous, P.W.; Redhead, S.A.; Reynolds, D.R.; Samson, R.A.; Seifert, K.A.; Taylor, J.W.; Wingfield, M.J.; Abaci, Ö.; Aime, C.; et al. The Amsterdam Declaration on Fungal Nomenclature. IMA Fungus 2011, 2, 105–112. [Google Scholar] [CrossRef]
- Heath, C.H.; Slavin, M.A.; Sorrell, T.C.; Handke, R.; Harun, A.; Phillips, M.; Nguyen, Q.; Delhaes, L.; Ellis, D.; Meyer, W.; et al. Population-based surveillance for scedopsporiosis in Australia: Epidemiology, disease manifestations and emergence of Scedosporium aurantiacum infection. Clin. Infect. Microbiol. 2009, 15, 689–693. [Google Scholar] [CrossRef] [PubMed]
- Johnson, L.S.; Shields, R.K.; Clancy, C.J. Epidemiology, clinical manifestations, and outcomes of Scedosporium infections among solid organ transplant recipients. Transpl. Infect. Dis. 2014, 16, 578–587. [Google Scholar] [CrossRef] [PubMed]
- Bronnimann, D.; Garcia-Hermoso, D.; Dromer, F.; Lanternier, F.; The French Mycoses Study Group. Scedosporiosis/lomentosporiosis observational study (SOS): Clinical significance of Scedosporium species identification. Med. Mycol. 2020. [Google Scholar] [CrossRef] [PubMed]
- Donnelly, J.P.; Chen, S.C.-A.; Kauffman, C.A.; Stienbach, W.J.; Baddley, J.W.; Verweij, P.E.; Clancy, C.J.; Wingard, J.R.; Lockhart, S.R.; Groll, A.H.; et al. Revision and update of the consensus definitions for invasive fungal disease from the European Organization for Research and Treatment of Cancer and the Mycoses Study Group Education and Research Consortium. Clin. Infect. Dis. 2020, 71, 1367–1376. [Google Scholar]
- Hoenigl, M.; Slamanton-Garcia, J.; Walsh, T.J.; Nucci, M.; Neoh, C.; Jenks, J.D.; Lackner, M.; Sprute, R.; Alhatmi, A.; Bassetti, M.; et al. Global guideline for the diagnosis and management of rare mold infections: An initiative of the ECMM in cooperation with ISHAM and ASM. Lancet. Infect. Dis. 2020. (Accepted; in Press). [Google Scholar]
- Guarner, J.; Brandt, M.E. Histopathologic diagnosis of fungal infections in the 21st century. Clin. Micrbiol. Rev. 2011, 24, 247–280. [Google Scholar] [CrossRef]
- Kimura, M.; Maenishi, O.; Ito, H.; Ohkusu, K. Unique histological characteristics of Scedosporium that could aid in its identification. Pathol. Int. 2010, 60, 131–136. [Google Scholar] [CrossRef] [PubMed]
- Hayden, R.T.; Isotalo, P.A.; Parrett, T.; Wolk, D.M.; Qian, X.; Roberts, G.D.; Lloyd, R.V. In situ hybridization for the differentiation of Aspergillus, Fusarium and Pseudallescheria in tissue section. Diagn. Mol. Pathol. 2003, 12, 21–26. [Google Scholar] [CrossRef] [PubMed]
- Albernaz, V.; Huston, B.; Castillo, M.; Mukerji, S.; Bouldin, T.W. Pseudallescheria boydii infection of the brain: Imaging with pathologic confirmation. Am. J. Neuroradiol. 1996, 17, 589–592. [Google Scholar] [PubMed]
- Rainer, J.; Kaltseis, J.; de Hoog, S.G.; Summerbell, R.C. Efficacy of a selective isolation procedure for members of the Pseudallescheria boydii complex. Ant. Leeuwenhoek. 2008, 93, 315–322. [Google Scholar] [CrossRef] [PubMed]
- Pham, T.; Giraud, S.; Schuliar, G.; Rougeron, A.; Bouchara, J.P. Scedo-Select III: A new semi-selective culture medium for detection of the Scedosporium apiospermum species complex. Med. Mycol. 2015, 53, 512–519. [Google Scholar] [CrossRef]
- King, A.D., Jr.; Hocking, A.D.; Pitt, J.I. Dichloran-rose bengal medium for enumeration and isolation of molds from foods. Appl. Environ. Microbiol. 1979, 37, 959–964. [Google Scholar] [CrossRef]
- Blyth, C.C.; Harun, A.; Middleton, P.G.; Sleiman, S.; Lee, O.; Sorrell, T.; Meyer, W.; Chen, S.C. Detection of occult Scedosporium species in respiratory tract specimens form patients with cystic fibrosis by use of selective media. J. Clin. Microbiol. 2010, 48, 314–316. [Google Scholar] [CrossRef]
- De Hoog, G.S.; Guarro, J.; Gene, J.; Ahmed, S.; Al-Hatmi, A.M.S.; Figueras, J.; Vitale, R.G. Atlas of Clinical Fungi, 3rd ed. Utrecht/Reus. 2019. Available online: http://www.clinicalfunig.org/ (accessed on 31 October 2020).
- Horre, R.; Schaal, K.P.; Marklein, G.; de Hoog, G.S.; Reiffert, S.M. Physiological typing of Psedualleascheria and Scedosporium strains using Taxa Profile, a semi-automated, 384-well microtiter system. Mycoses 2011, 54, 56–65. [Google Scholar] [CrossRef]
- Kaur, J.; Duan, S.Y.; Vaas, L.A.I.; Penesyan, A.; Meyer, W.; Paulsen, I.; Nevalainen, H. Phenotypic profiling of Scedosporium aurantiacum, an opportunistic pathogen colonizing human lungs. PLoS ONE 2015, 10, e0122354. [Google Scholar] [CrossRef]
- Wilkendorf, L.S.; Bowles, E.; Buil, J.B.; van der Lee, H.A.L.; Posteraro, B.; Sanguientti, M.; Verweij, P.E. Update on MALDI-TOF MS identification of filamentous fungi. J. Clin. Microbiol. 2020. [Google Scholar] [CrossRef]
- Patel, R. A moldy application of MALDI: MALDI-TOF mass spectrometry for fungal identification. J. Fungi 2019, 5, 4. [Google Scholar] [CrossRef] [PubMed]
- Pinheiro, D.; Monteiro, C.; Faria, M.A.; Pinto, E. VitekR MS v3.0 system in the identification of filamentous fungi. Mycopathologia 2019, 184, 645–651. [Google Scholar] [CrossRef] [PubMed]
- Sleiman, S.; Halliday, C.; Chapman, B.; Brown, M.; Nitschke, J.; Lau, A.F.; Chen, S.C.-A. Performance of matrix-assisted laser desorption ionization-time of flight mass spectrometry for identification of Aspergillus, Scedosporium and Fusarium spp. in the Australian clinical setting. J. Clin. Microbiol. 2016, 54, 2182–2186. [Google Scholar] [CrossRef] [PubMed]
- Bernhard, M.; Zautner, A.E.; Steinmann, J.; Weig, M.; GroB, U.; Bader, O. Towards proteomic species barcoding of fungi—An example using Scedosporium/Pseudallescheria complex isolates. Fungal. Biol. 2016, 120, 162–165. [Google Scholar] [CrossRef]
- Sitterle, E.; Giraud, S.; Leto, J.; Bouchara, J.P.; Rougeron, A.; Morio, F.; Bougnoux, M.E. matrix-assisted laser desorption ionization-time of flight mass spectrometry for fast and accurate identification of Pseudallescheria/Scedosporium species. Clin. Microbiol. Infect. 2014, 20, 929–935. [Google Scholar] [CrossRef]
- Lau, A.F.; Walchak, R.C.; Miller, H.B.; Slechta, E.S.; Kamboj, K.; Rieebe, K.; Frank, K.M. Multicenter study demonstrates standardization requirements for mold identification by MALDI-TOF MS. Front. Microbiol. 2019, 10. [Google Scholar] [CrossRef]
- Zvezdanova, M.E.; Escribano, P.; Riuz, A.; Martinez-Jimenez, M.C.; Pepaez, T.; Ccollazos, A.; Rodriguez-Sanchez, B. Increased species assignment of filamentous fungi using MALDI-TOF MS coupled with simplified sample processing and an in-house library. Med. Mycol. 2018, 57, 63–70. [Google Scholar] [CrossRef]
- Irinyi, L.; Serena, C.; Garcia-Hermoso, D.; Arabatzis, M.; Desnos-Ollivier, M.; Vu, D.; Cardindi, G.; Arthur, I.; Normand, A.-C.; Giraldo, A.; et al. International Society of Human and Animal Mycology (ISHAM)-ITS reference DNA barcoding database: The quality controlled standard tool for routine identification of human and animal pathogenic fungi. Med. Mycol. 2015, 53, 313–337. [Google Scholar] [CrossRef]
- Matray, O.; Mouhajir, A.; Giraud, S.; Gordon, C.; Gargala, G.; Labbe, F.; Rougeron, A.; Ballet, J.J.; Zouhair, R.; Bouchara, J.-P. Semi-automated repetitive sequence-based PCR amplification for species of the Scedosporium apiospermum complex. Med. Mycol. 2016, 54, 409–419. [Google Scholar] [CrossRef]
- Bernhardt, A.; Sedlacek, L.; Wagner, S.; Schwarz, C.; Wurstl, B.; Tintelnot, K. Multilocus sequence typing of Scedosporium apiospermum and Pseudallescheria boydii isolates from cystic fibrosis patients. J. Cyst. Fibros. 2013, 12, 592–598. [Google Scholar] [CrossRef]
- Demidov, V.V. Rolling circle amplification in DNA diagnostics: The power of simplicity. Expert. Rev. Mol. Diagn. 2002, 2, 542–548. [Google Scholar] [CrossRef] [PubMed]
- Zhou, X.; Kong, F.; Sorrell, T.C.; Wang, H.; Daun, Y.; Chen, S.C. Practical method for detection and identification of Candida, Aspergillus and Scedosporium spp. by use of rolling circle amplification. J. Clin. Microbiol. 2008, 46, 2423–2427. [Google Scholar] [CrossRef] [PubMed]
- Kidd, S.; Chen, S.C.-A.; Meyer, W.; Halliday, C. A new age in molecular diagnostics for invasive fungal diseases: Are we ready? Front. Microbiol. 2020. [Google Scholar] [CrossRef]
- Sabino, R.; Simoes, H.; Verissimo, C. Detection of deep fungal infections: A polyphasic approach. J. Med. Microbiol. 2019, 68, 81–86. [Google Scholar] [CrossRef]
- Gomez, C.A.; Budvytuene, I.; Zenek, A.J.; Banal, N. Performance of targeted fungal sequencing for culture-independent diagnosis of invasive fungal disease. Clin. Infect. Dis. 2017, 65, 2035–2041. [Google Scholar] [CrossRef] [PubMed]
- White, T.J.; Bruns, T.; Lee, S.; Taylor, J.W. Amplification and Direct Sequencing of Fungal Ribosomal RNA Genes for Phylogenetics. In PCR Protocols: A Guide to Methods and Applications; Innis, M.A., Gelfand, D.H., Sninsky, J.J., White, T.J., Eds.; Academic Press: New York, NY, USA, 1990; pp. 315–322. [Google Scholar]
- Lau, A.; Chen, S.; Sorrell, T.; Martin, P.; Malik, R.; Carter, D.; Halliday, C. Development and clinical application of a panfungal PCR assay to detect and identify fungal DNA in tissue specimens. J. Clin. Microbiol. 2007, 45, 380–385. [Google Scholar] [CrossRef]
- Valero, C.; de la Cruz-Villar, L.; Zaragoza, O.; Buitrago, M.J. New panfungal real-time PCR assay for diagnosis of invasive fungal infections. J. Clin. Microbiol. 2016, 54, 2910–2918. [Google Scholar] [CrossRef]
- Salehi, E.; Hedayati, M.T.; Zoll, J.; Rafati, H.; Ghasemi, M.; Doroudinia, A.; Abastabar, M.; Tolooe, A.; Snelders, E.; van der Lee, H.A.; et al. Discrimination of aspergillosis, mucormycosis, fusariosis and scedosporiosis in formalin-fixed paraffin-embedded tissue specimens by use of multiple real-time quantitative PCR assays. J. Clin. Microbiol. 2016, 11, 2798–2903. [Google Scholar] [CrossRef]
- Zeller, I.; Schabereiter-Gurtner, C.; Mihaltis, V.; Selitsch, B.; Barousch, W.; Hirschi, A.M.; Makristathis, A.; Willinger, B. Detection of fungal pathogens by a new broad range real time PCR assay targeting the fungal ITS region. J. Med. Microbiol. 2017, 16, 1383–1392. [Google Scholar] [CrossRef]
- Trubiano, J.A.; Dennison, A.M.; Morrissey, C.O.; Chua, K.Y.; Halliday, C.L.; Chen, S.C.-A. Clinical utility of panfungal polymerase chain reaction for the diagnosis of invasive fungal disease: A single centre experience. Med. Mycol. 2016, 54, 138–146. [Google Scholar] [CrossRef]
- Harun, A.; Blyth, C.C.; Gilgado, F.; Middleton, P.; Chen, S.C.; Meyer, W. Development and validation of a multiplex PCR for detection of Scedosporium spp. in respiratory tract specimens form patients with cystic fibrosis. J. Clin. Microbiol. 2011, 49, 1508–1512. [Google Scholar] [CrossRef] [PubMed]
- Castelli, M.V.; Buitrago, M.J.; Bernal-Martinez, L.; Gomez-Lopez, A.; Rodriguez-Tudela, J.L.; Cuenca-Estrella, M. Development and validation of a quantitative PCR assay for diagnosis of scedosporiosis. J. Clin. Microbiol. 2008, 46, 3412–3416. [Google Scholar] [CrossRef] [PubMed]
- Bouchara, J.P.; Hsieh, H.Y.; Croquefer, S.; Barton, R.; Marchais, V.; Pihet, M.; Chang, T.C. Development of an oligonucleotide assay for direct detection of fungi in sputum samples from patients with cystic fibrosis. J. Clin. Microbiol. 2009, 47, 142–152. [Google Scholar] [CrossRef] [PubMed]
- He, S.; Hang, J.P.; Zhang, L.; Wang, F.; Zhang, D.C.; Gong, F.H. A systematic review and meta-analysis of diagnostic accuracy of serum 1,3-β-D-glucan for invasive fungal infection: Focus on cutoff levels. J. Microbiol. Immunol. Infect 2015, 48, 351–356. [Google Scholar] [CrossRef] [PubMed]
- Karageorgopoulos, D.E.; Voulouman, E.K.; Nziora, F.; Michalpoulos, A.; Rafailidos, P.I.; Falagas, M.E. β-D-glucan assay for the diagnosis of invasive fungal infections: A meta-analysis. Clin. Infect. Dis. 2011, 52, 750–770. [Google Scholar] [CrossRef]
- Cuerara, M.S.; Alhambra, A.; Moragues, M.; Gonzalez-Elorza, E.; Ponton, J.; de Palacio, A. Detection of (1,2)-β-D-glucan as an adjunct to diagnosis in a mixed population with uncommon proven invasive fungal diseases or with an unusual clinical presentation. Clin. Vaccine. Immunol. 2009, 16, 423–426. [Google Scholar]
- Levesque, E.; Rizk, F.; Noorah, Z.; Ait-Ammar, N.; Cordonnier-Jourdin, C.; El-Anbassi, S.; Bonnal, C.; Azoulay, D.; Merle, J.-C.; Botterel, F. Detection of (1,3)-β-D-glucan for the diagnosis of invasive fungal infection in liver transplant recipients. Int. J. Mol. Sci. 2017, 18, 862. [Google Scholar] [CrossRef]
- Nishimori, M.; Takahashi, T.; Suzuki, E.; Kodaka, T.; Hiramoto, N.; Itoh, K.; Tsunemine, H.; Yarita, K.; Kamei, K.; Takegawa, H.; et al. Fatal fungemia with Scedosporium prolificans in a patient with acute myeloid leukemia. Med. Mycol. J. 2014, 55E, E63–E70. [Google Scholar] [CrossRef]
- Thornton, C.R.; Ryder, L.S.; Le Cocq, K.; Soanes, D.M. Identifying the emerging human pathogen Scedosporium prolificans by using a species-specific monoclonal antibody that bind to the melanin biosynthetic enzyme tetrahydroxynaphthalene reductase. Environ. Microbiol. 2015, 17, 1023–1039. [Google Scholar] [CrossRef]
- Thornton, C.R. Tracking the emerging human pathogen Pseudallescheria boydii by using high specific monoclonal antibodies. Clin. Vaccine. Immunol. 2009, 16, 756–7645. [Google Scholar] [CrossRef]
- Mina, S.; Marot-Leblond, A.; Cimon, B.; Fleury, M.J.J.; Larcher, G.; Bouchara, J.-P. Purification and characterization of a mycelial catalase from Scedosporium boydii, a useful tool for specific antibody detection in patients with cystic fibrosis. Clin. Vaccine. Immunol. 2015, 22, 37–45. [Google Scholar] [CrossRef] [PubMed]
- Pluhacek, T.; Lemr, K.; Ghosh, D.; Milde, D.; Novak, J.; Havlicek, V. Characterization of microbial siderophores by mass spectrometry. Mass. Spectrom. Rev. 2016, 35, 35–47. [Google Scholar] [CrossRef] [PubMed]
- Halliday, C.L.; Chen, S.C.; Kidd, S.E.; van Hal, S.; Chapman, B.; Heath, C.H.; Lee, A.; Kennedy, K.; Daveson, K.; Sorrell, T.C.; et al. Antifungal susceptibilities of non-Aspergillus filamentous fungi causing invasive infection in Australia: Support for current antifungal guideline recommendations. Int. J. Antimicrob. Agents. 2016, 48, 453–458. [Google Scholar] [CrossRef] [PubMed]
- Lackner, M.; De Hoog, G.S.; Verweij, P.E.; Najafzadeh, M.; Curfs-Breuker, I.; Klassen, C.; Meis, J. Species-specific antifungal susceptibility patterns of Scedosporium and Pseudallescheria species. Antimicrob. Agents Chemother. 2012, 56, 2635–2642. [Google Scholar] [CrossRef] [PubMed]
- Alastruey-Izuierdo, A.; Alcazar-Fuoli, L.; Rivero-Menendez, O.; Ayats, J.; Castro, C.; Garcia-Rodriguez, J.; Goterris-Bonet, L.; Ibanez-Martinez, E.; Linares-Sicilia, M.J.; Martin-Gomez, M.T.; et al. Molecular identification and susceptibility testing of molds in a prospective surveillance of triazole resistance in Spain (FILPOP2 Study). Antimicrob. Agents. Chemother. 2018, 62, e00358-18. [Google Scholar] [CrossRef]
- Pellon, A.; Ramirez-Garcia, A.; Buldain, I.; Antoran, A.; Martin-Souto, L.; Rementeria, A.; Hernando, F. Pathobiology of Lomentospora prolificans: Could this species serve as a model of primary antifungal resistance? Int. J. Antimicrob. Agents 2018, 51, 10–15. [Google Scholar] [CrossRef]
- Sedlacek, L.; Graf, B.; Schwarz, C.; Albert, F.; Peter, S.; Wurstl, B.; Wagner, S.; Klotz, M.; Becker, A.; Haase, G.; et al. Prevalence of Scedosporium species and Lomentospora prolificans in patients with cystic fibrosis in a multicentre trial by use of a selective medium. J. Cyst. Fibros. 2015, 14, 237–241. [Google Scholar] [CrossRef]
- Trovato, L.; Scalia, G.; Palermo, C.I.; Costanzo, C.M.; Oliveri, S. Evaluation of isavuconazole MICs trips for susceptibility testing of Aspergillus and Scedosporium species. Med. Mycol. 2019, 57, 429–433. [Google Scholar] [CrossRef]
- Jenks, J.D.; Seidel, D.; Cornely, O.A.; Chen, S.; van Hal, S.; Kauffman, C.; Miceli, M.; Heinemann, M.; Christner, M.; Jover-Saenz, A.; et al. Voricoanzole plus terbinafine combination antifungal therapy for invasive Lomentospora prolificans infections; analysis of 41 patients from the FungiScope R registry, 2008–2019. Clin Microbiol Infect 2020, 26, 784.e1–784.e5. [Google Scholar] [CrossRef]
- Blyth, C.C.; Gilroy, N.M.; Guy, S.D.; Chambers, S.T.; Cheong, E.Y.; Gottlieb, T.; McGuiness, S.L.; Thursky, K.A. Consensus guidelines for the treatment of invasive mold infections in hematological malignancy and hematopoeitic stem cell transplantation, 2014. Int. Med. J. 2014, 44, 1333–1345. [Google Scholar] [CrossRef]
- Shaw, K.J.; Ibrahim, A.S. Fosmanogepix: A review of the first-in-class broad spectrum agent for the treatment of invasive fungal infections. J. Fungi 2020, 6, 239. [Google Scholar] [CrossRef] [PubMed]
- Castaheira, M.; Duncanson, F.P.; Diekema, D.J.; Guarro, J.; Jones, R.N.; Pfaller, M.A. Activities of E1210 and comparator agents tested by CLSI and EUCAST broth microdilution methods against Fusarium and Scedosporium species identified using molecular methods. Antimicrob. Agents Chemother. 2012, 56, 352–357. [Google Scholar] [CrossRef] [PubMed]
- Oliver, J.D.; Sibley, G.E.; Beckmann, N.; Dobb, K.S.; Slater, M.J.; McEntee, L.; du Pre, S.; Livermore, J.; Bronley, M.J.; Wiederhold, N.P.; et al. F901318 represents a novel class of antifungal drug that inhibits dihydro-ororate dehydrogenase. Proc. Natl. Acad. Sci. USA 2016, 113, 12809–12814. [Google Scholar] [CrossRef] [PubMed]
- Wiederhold, N.; Law, D.; Birch, M. Dihydroorotate dehydrogenase inhibitor F901318 has potent in vitro activity against Scedosporium species and Lomentospora prolificans. J. Antimicrob. Chemother. 2017, 27, 1977–1980. [Google Scholar] [CrossRef] [PubMed]
- Nagl, M.; Mair, C.; Dietrich, H. Tolerability of inhaled N-chlorotaurine versus sodium chloride in the mouse. J. Med. Res. Prac. 2013, 2, 163–170. [Google Scholar]
- Luo, R.; Zimin, A.; Workman, R.; Fan, Y.; Pertea, G.; Grossman, N.; Wear, W.; Jia, B.; Miller, H.; Casadevall, A.; et al. First draft genome sequence of the pathogenic fungus Lomentospora prolificans (formerly Scedosporium prolificans). G3 2017, 7, 3831–3836. [Google Scholar] [CrossRef]
- Duvaux, L.; Shiller, J.; Vanderputte, P.; De Bernonville, T.; Thornton, C.; Papon, N.; Le Cam, B.; Bouchara, J.P.; Gastebois, A. Draft genome sequence of the human pathogenic fungus Scedosporium boydii. Genome Announc. 2017, 5, e00871-17. [Google Scholar] [CrossRef]
- Vendeputte, P.; Ghamrawi, S.; Rechenmann, M.; Iltis, A.; Giraud, S.; Fleury, M.; Thornton, C.; Delhaes, L.; Meyer, W.; Papon, N.; et al. Draft genome sequence of the pathogenic fungi Scedosporium apiospermum. Genome. Announc. 2014, 2, 10–11. [Google Scholar]
- Perez-Bercoff, A.; Papanicolaou, A.; Ramsperger, M.; Kaur, J.; Patel, H.R.; Harun, A.; Duan, S.Y.; Elbourne, L.; Bouchara, J.P.; Paulsen, I.T.; et al. Draft genome of Australian environmental strain WM09.24 of the opportunistic human pathogen Scedosporium aurantiacum. Genome Announc. 2015, 3, e01526-14. [Google Scholar] [CrossRef]
- Boan, P.; Pang, S.; Gardam, D.J.; Darragh, H.; Wright, M.; Coombs, G.W. Investigation of a Lomentospora prolificans case cluster with whole genome sequencing. Med. Mycol. Case. Rep. 2020, 29, 1–4. [Google Scholar] [CrossRef]
Publisher’s Note: MDPI stays neutral with regard to jurisdictional claims in published maps and institutional affiliations. |
© 2021 by the authors. Licensee MDPI, Basel, Switzerland. This article is an open access article distributed under the terms and conditions of the Creative Commons Attribution (CC BY) license (http://creativecommons.org/licenses/by/4.0/).